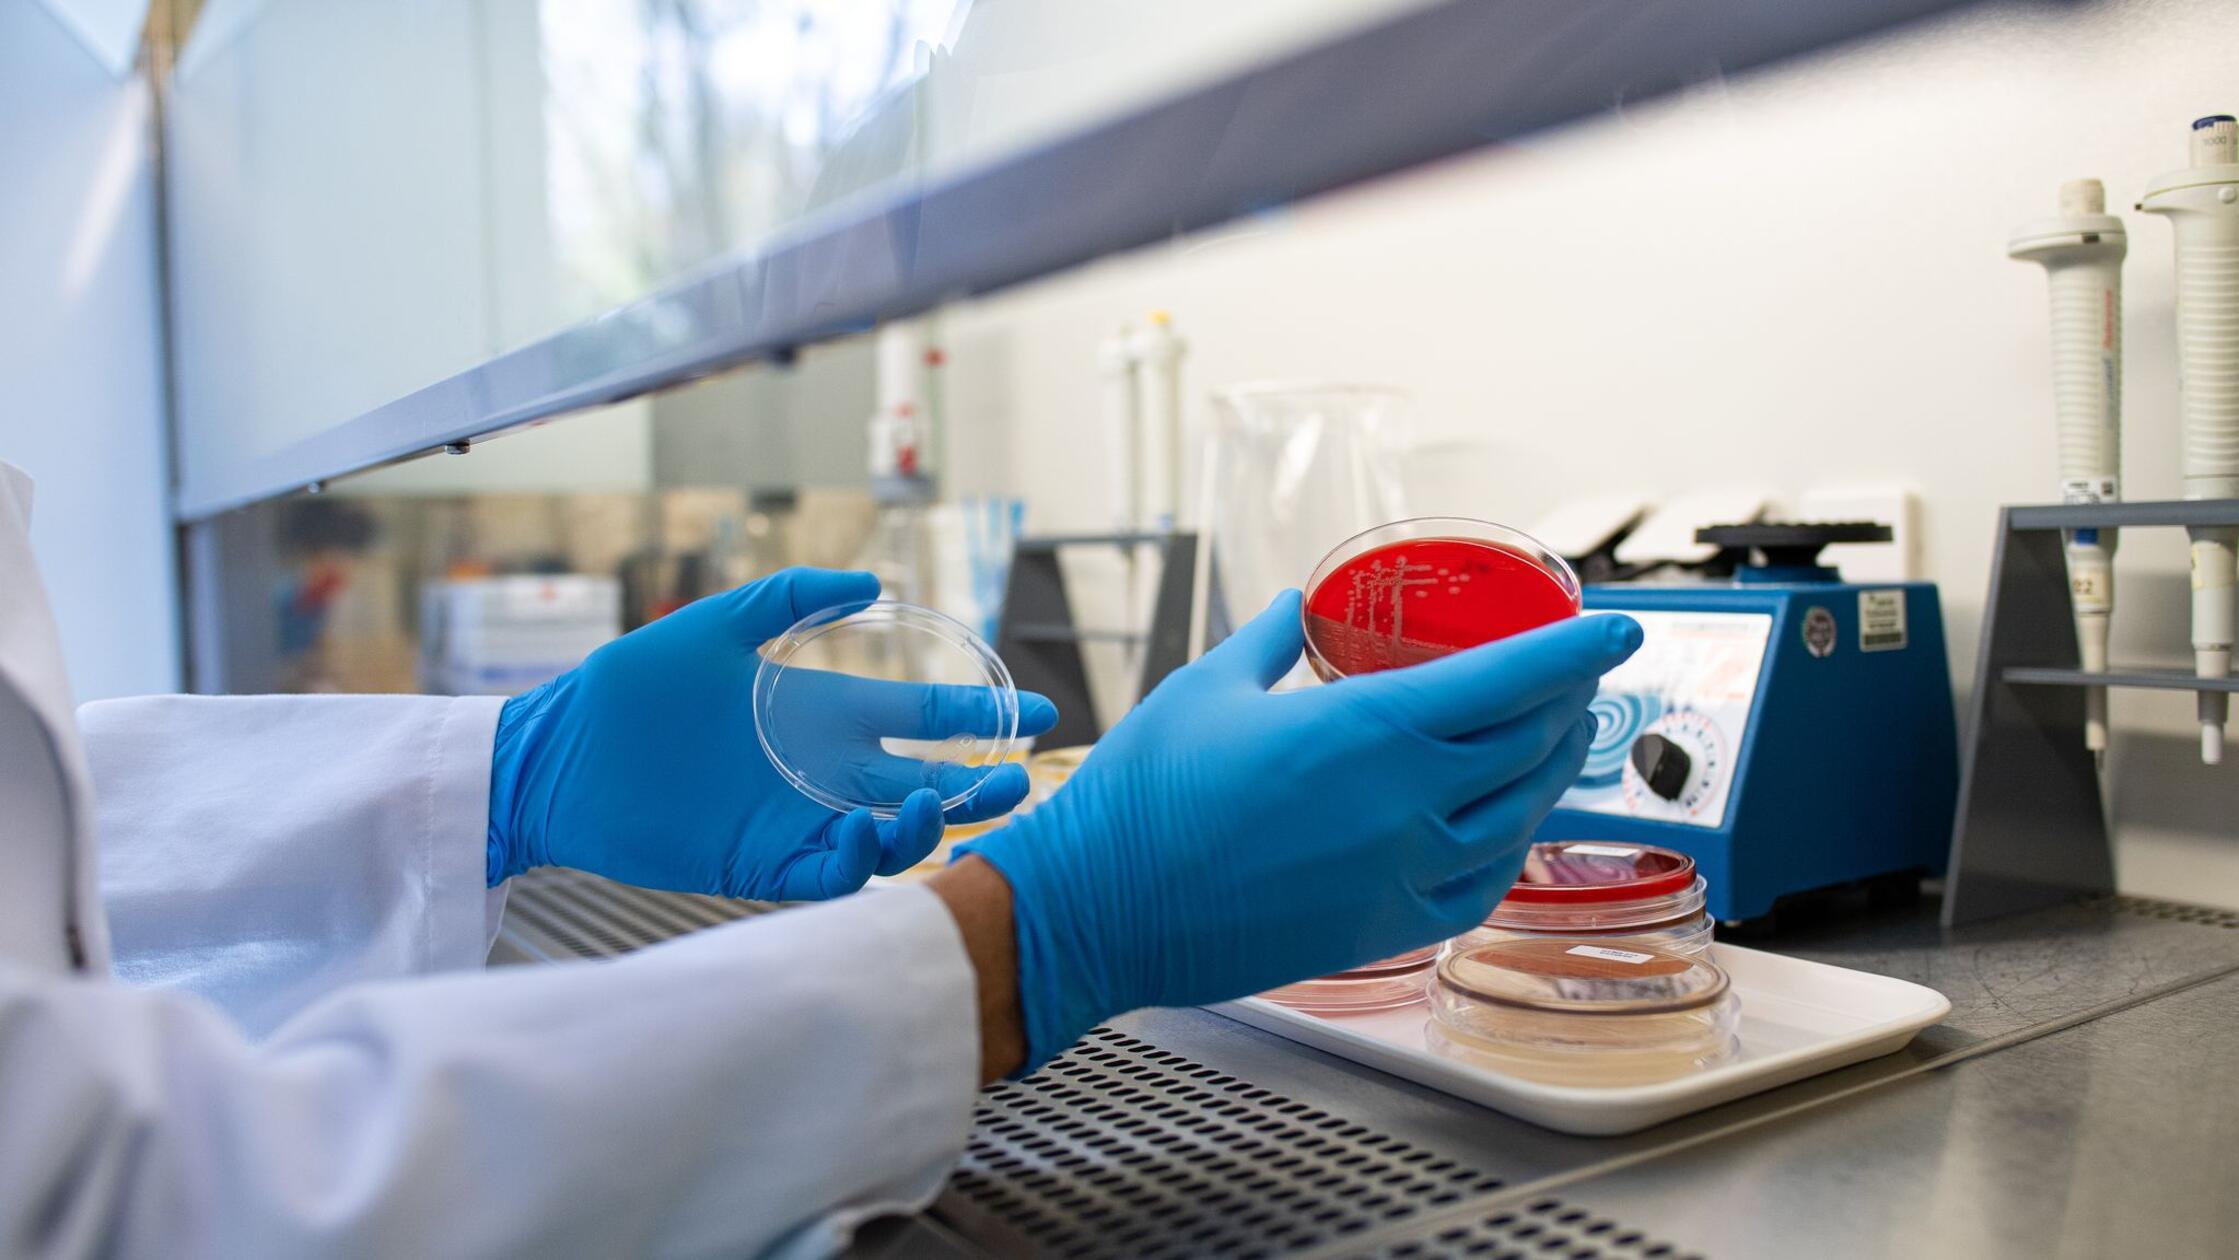
Fünf weitere Ehec-Infektionen in Vorpommern

V Rusiji porast okužb z meningokokno boleznijo v letu 2025, a so preprečili večje izbruhe
19. nov 20:56
Ruski nadzorni organ za varstvo potrošnikov, Rospotrebnadzor, je ocenil, da je v Rusiji od začetka leta 2025 prišlo do porasta okužb z meningokokno boleznijo. Kljub temu so s sprejetimi ukrepi uspeli preprečiti nadaljnje širjenje in večje gručne izbruhe bolezni.